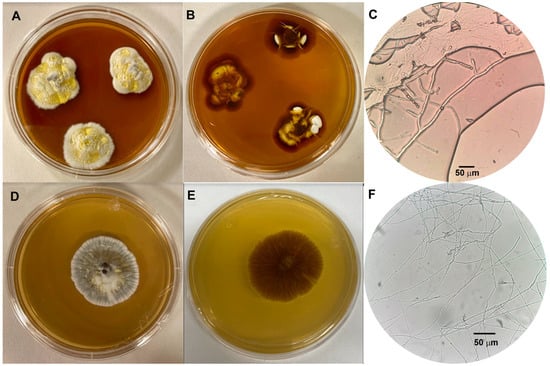
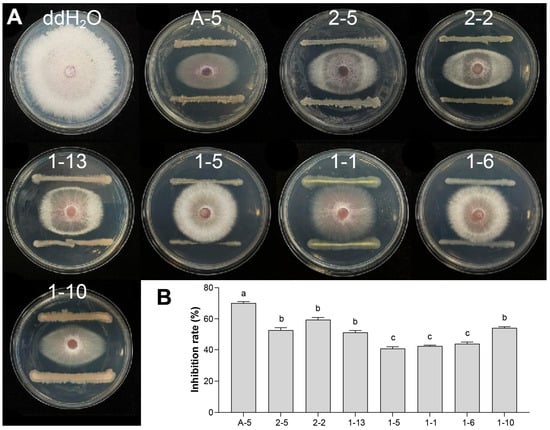

-
 Development of Mycoinsecticides: Advances in Formulation, Regulatory Challenges and Market Trends for Entomopathogenic Fungi
Development of Mycoinsecticides: Advances in Formulation, Regulatory Challenges and Market Trends for Entomopathogenic Fungi -
 Zinc-Finger 5 Is an Activation Domain in the Saccharomyces cerevisiae Stress-Responsive Transcription Factor Fzf1
Zinc-Finger 5 Is an Activation Domain in the Saccharomyces cerevisiae Stress-Responsive Transcription Factor Fzf1 -
 Identification and Classification of Fungal GPCR Gene Families
Identification and Classification of Fungal GPCR Gene Families -
 Genetic Manipulation in Sporothrix Species: Molecular Tools, Challenges, and Applications
Genetic Manipulation in Sporothrix Species: Molecular Tools, Challenges, and Applications -
 Comparative Mitogenomics Reveals Intron Dynamics and Mitochondrial Gene Expression Shifts in Domesticated and Wild Pleurotus ostreatus
Comparative Mitogenomics Reveals Intron Dynamics and Mitochondrial Gene Expression Shifts in Domesticated and Wild Pleurotus ostreatus
Journal Description
Journal of Fungi
- Open Access— free for readers, with article processing charges (APC) paid by authors or their institutions.
- High Visibility: indexed within Scopus, SCIE (Web of Science), PubMed, PMC, CAPlus / SciFinder, AGRIS, and other databases.
- Journal Rank: JCR - Q1 (Mycology) / CiteScore - Q1 (Ecology, Evolution, Behavior and Systematics)
- Rapid Publication: manuscripts are peer-reviewed and a first decision is provided to authors approximately 19 days after submission; acceptance to publication is undertaken in 2.8 days (median values for papers published in this journal in the second half of 2025).
- Recognition of Reviewers: reviewers who provide timely, thorough peer-review reports receive vouchers entitling them to a discount on the APC of their next publication in any MDPI journal, in appreciation of the work done.
- Journal Cluster of Microbiology: Acta Microbiologica Hellenica, Applied Microbiology, Bacteria, Journal of Fungi, Microorganisms, Microbiology Research, Pathogens and Viruses.
Latest Articles
Highly Accessed Articles
Latest Books
E-Mail Alert
News
Topics
Deadline: 31 July 2026
Deadline: 30 November 2026
Deadline: 1 March 2027
Deadline: 30 June 2027
Conferences
Special Issues
Deadline: 10 April 2026
Deadline: 10 April 2026
Deadline: 10 April 2026
Deadline: 30 April 2026